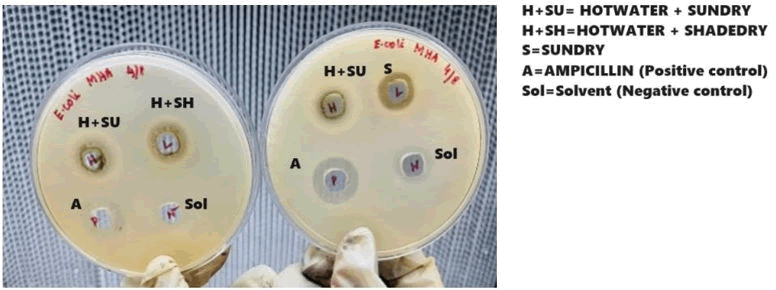
XXXXXXXXXXXX XXXXXXXXXXXX
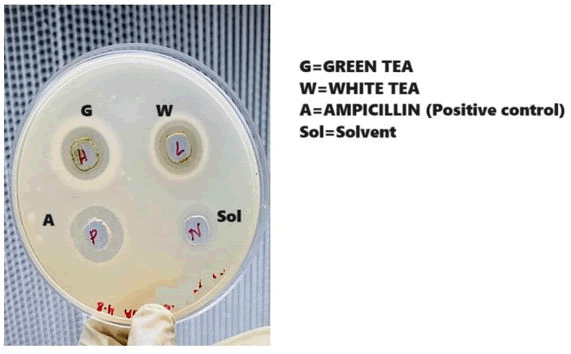
XXXXXXXXXXXX XXXXXXXXXXXX

Research Article - Journal of Food Technology and Preservation (2025) Volume 9, Issue 2
Importance of handcrafting methods on quality of tea.
Sudeshna Shyam Choudhury*, Debapriya Maitra, Bedaprana Roy, Sejuti Roy, Sony Choubey, Anindita Roy Chowdhury, Bipasha Saha, Anwesha Biswas, Abhas Chatterjee, Sruti Thakur, Srimoyee Sen, Biswanath Ganguly, Arup Kumar Mitra
Department of Microbiology, St. Xavier’s College, Kolkata, India
- *Corresponding Author:
- Sudeshna Shyam Choudhury
Department of Microbiology,
St. Xavier’s College, Kolkata,
India
E-mail: sudeshna.s.choudhury@sxccal.edu
Received: 07-Aug-2024, Manuscript No. AAFTP-24-144761; Editor assigned: 12-Aug-2024, AAFTP-24-144761 (PQ); Reviewed: 27-Aug-2024, QC No. AAFTP-24-144761; Revised: 08-Apr-2025, Manuscript No. AAFTP-24-144761 (R); Published: 15-Apr-2025, DOI: 10.35841/2591-796X-9.2.282
Citation: Choudhury SS, Maitra D, Roy B, et al. Importance of handcrafting methods on quality of tea. J Food Technol Pres 2025;9(2):282
Abstract
Differential drying methods produce different types of handcrafted teas. Freshly harvested teas collected from VVTEA farm, Fatapukur, Jalpaiguri are taken for different types of drying processes including only viz. only sundrying, hotwater treated sundrying, hotwater treated shadedrying processes. Industrial processing of white tea could be corroborated with only sundrying and hotwater with drying methods could be correlated with the steaming process of industrially prepared green tea. Handcrafted teas are made by small growers which also contributes towards economic value of North Bengal grown tea. Different types of such drying methods have contributed towards different quality parameters like commercial qualities viz. color, aroma and therapeutic values like antioxidant, antimicrobial potentials.
The commercial and therapeutic values are indicated by the biochemical quality parameters like polyphenols or catechins (standards like gallic acid, epigallocatechin gallate) flavonoids (standards like rutin, quercetin etc.). Evaluation of such quality parameters were observed by different bioinstrumentation techniques like FTIR, HPLC, TLC, spectrophotometric scan, E-nose measurement. Physico-chemical parameters like moisture content and ash contents ate also indicator of quality parameters of handcrafted teas. In this paper such physic-chemical and biochemical evaluation of quality parameters indicates the best method as hotwater and sundrying handcrafted process which is equivalent to commercially available green tea.
Keywords
Sundry, Shade dry, Hot water, HPLC, TLC, FTIR, Tea.
Introduction
Tea is most popular beverage in the world made from the plant Camellia sinnesis. Apart from this it acts as therapeutic drink showing antioxidant, antimicrobial and anticancer potential [1]. According to manufacturing process four types of teas are most abundant [2] made from freshly harvested leaves. Polyphenol oxidase oxidises (fermentation) catechins (like epigallocatechin gallate) to tannins (theflavin, thearubigin which are responsible for brown liquor colour). Black tea is fully fermented showing full enzymatic oxidation, oolong tea is semifermented [3]. White tea is only withered not allowing the enzymatic oxidation (fermentation to happen), as they are only withered there is lesser chance of catechin oxidation. The catechins are the marker biochemical belongs to polyphenols group which are responsible to show therapeutic values like antioxidant, antimicrobial potentials. Gallic acid is the polyphenol found in all types of tea but varies in different types whereas rutin, quercetin are the flavonoids which are also found in different types of tea in different amount imparting antioxidant and antimicrobial potentials [4]. Whereas in case of green tea the fermentation that is the oxidation of catechins with polyphenol oxidase enzyme is terminated very early by inhibiting the enzyme with steaming, so catechins are not fully transformed causing to impart pale yellow colour of liquor [5]. In some handcrafting method of tea processing, the blanching is alternate process of steaming. Hence the process preserves the catechin colours and structures to promote health benefits [6].
There are 30,000 such small tea growers in North Bengal and total production is around 91 million kg, which is almost 32.5% of North Bengal's tea production of 280 million kg.
Bought-leaf factories are units that buy these tea leaves and convert them into the processed tea. Jalpaiguri is one of the district which is called as the land of tea, timber, and tourism in the Dooars region of North Bengal, contributes a huge manufactured tea including CTC and orthodox types, along with that small tea growers are also involved to make handcrafted tea which not only contribute to the economic value for tea production but also establishes its value which is comparable to the factory-made (machine processed) tea according to the commercial and medicinal qualities [7].
Handmade or handcrafted tea are popular today which increases popularity of small growers and could increase the economy of cottage industry. Handcrafted tea can include the method like only withering or sun drying just mimicking the white tea industrial preparation. Other handcrafted tea methods include blanching and shade drying or sun drying, methods which are just small scale processing of green tea [8].
The drying process of beverages and food is of concerned in recent years which could change the quality. Natural drying (drying in the shade or in the sun) are the most widely used methods because of their lower cost. Evaluation of drying methods like shade drying and sun drying and only drying without blanching could change the qualities of tea like total polyphenols, flavonoids content, antioxidant and antimicrobial potential. FTIR, HPLC, TLC, spectrophotometric scan are the bioinstrumentation techniques which could differentiate all those quality parameters in different teas [9]. The ash content, moisture content reflects the physicochemical status of manufactured/processed tea. In all the cases the handcrafted processing methods could also change the shelf lives and quality of tea.
This paper aims to evaluate the commercial and therapeutic qualities of different handcrafted tea processed differentially like only sundry, hotwater treatment followed by either sundry or shadedry which further can elevate the economic (by encouraging small growers) and medicinal value of North Bengal grown tea.
Materials and Methods
Materials
The handcrafted teas were prepared, collected and contributed from VVTEA farm, Fatapukur, Jalpaiguri from TV 25 tea clones. The freshly harvested autumn flush teas were differentiated into three sets, one set is only sundried (just like only withering as white tea is manufactured) and other two were sundried and shade dried after hot water treatment as blanching.
Drying process: Sun drying was made at normal ambient temperature at 34?C for 3 days (8 am-3 pm 7 hours daily) and then was packaged. The hot water treatment was done by boiling in earthen pot for 1 hour then sundried for 3 hours (1 pm-4 pm) daily for three days, shade dry treatment was given in a room of ambient temperature for 3 hours daily for 3 days Figures 1-4.
Figure 1. Different types of tea manufacturing process (handcrafted) had done in VVTEA farm, Fatapukur, Jalpaiguri.
Figure 2. Transformation of leaves by sun drying.
Figure 3. Different types of postharvest dried tea.
Figure 4. Commercially available white and green tea.
Preparation of tea extracts
All the tea samples were weighed as 500 mg and extracted in methanol (20 ml) by maceration methods with morter pestle and after maceration the solutions are centrifuged at 5000 rpm for 15 minutes then the supernatant was collected to use in the experiments. All the experiments were monitored initially and then monthly upto five months’ period.
Moisture and ash content determination (Physicochemical paramaters)
Moisture content was measured by using hot air oven at temperature of 105°C and ash content was measured according to Srilakshmi, by using muffle furnace at 500-600°C for 5-6 hrs (Table 1).
| Manufactured type | Total ash content | Moisture content |
| Sun dry | 5 ± 0.036% | 8 ± 0.001% |
| Hot water+sundry | 4.1 ± 0.02% | 3.1 ± 0.002% |
| Hot water+shadedry | 4.2 ± 0.03% | 3.5 ± 0.001% |
| Green tea | 4 ± 0.057% | 3 ± 0.001% |
| White tea | 5.1 ± 0.06% | 8.9 ± 0.002% |
Table 1. Physico-chemical parameters of tea.
Total polyphenol content
The total polyphenol contents are determined according to the Anesini et al. In 1 ml of each extract 4 ml of 1 M Na2CO3 and 1 ml of Folin Ciocaltau phenol reagent is added. The absorbance is taken at 765 nm. Gallic acid was used as standard. The results were expressed in terms of mg/ml gallic acid equivalent.
Total flavonoid content
The flavonoid assay was done according to Zhishen et al., by mixing the tea extracts with 75 μl of 5% Na2CO3, 150 μl of 10% of AlCl3, 750 μl of NaOH and 2500 μl of water, and the O.D was measured at 510 nm.
FTIR analysis
FTIR analysis has been used to determine level of flavonoids in different types of tea leaves. The spectral scan was done between 200-500 nm wavelength. The excitation wavelength was given at 360 nm whereas the emission peak was observed at 460 nm. It was done according to Kokalj et al.
Spectrophotometric scan analysis
U-2900 Spectrophotometer was used for the spectral scan of tea samples. The spectral scan was run from 500 nm till 200 nm with the scan speed of 400 nm/min, sampling interval of 0.5 nm and slit width of 1.50 nm. Gallic acid is taken as standard.
HPLC analysis
HPLC analysis was done in Waters® Empower™ 3 with C 18 column (injection volume 50 µl, runtime 15 minutes, (Channel name W2489ChA), the eluent was monitored at 285 nm, Rutin was taken as standard.
Thin layer chromatography
TLC assay was done in silica plate with (by using solvents butanol: acetone: acetic acid 5:5:3 v/v) sprayed with specific colorimetric agents like iron chloride and ethanol reagent after that densitometric scan was done.
Total antioxidant activity assay
Antioxidant potential is assayed (according to Rebeiro et al. by taking 1 ml of the tea sample extracts and the percent reduction of 0.004% DPPH solution in MeOH is assayed at 517 nm absorbance by spectrophotometer.
Measurement of tea colour
The tea colour was measured according to Goodner and Wampler, measured hue at 460 nm wavelength.
pH determination
pH of different solutions of tea were measured according to Saadeh et al.
Catechin content
Tea extracts of 0.1 ml of were mixed with 2 ml of ethanolic vanillin solution. Ethanol and HCl (1:1 v/v) was added to the mixture to a total volume of 10 ml. After 15 min, the absorbance of the solution was measured at 520 nm. Epigallocatechin Gallate (1 mg/ml) is taken as standard.
E-nose analysis
E-nose and E tongue data analysis the E-nose data were determined in terms of Taster’s Score (TS) and Noraroma Index (NI).
Antimicrobial activity
The antimicrobial testes were done according to Bose and Bose by doing Agar cup plate method against E. coli and the zone of inhibition were measured after 24 hours.
Ampicillin solution (5 mg/ml) is taken as positive control and as negative control solvent (methanol) in each case. The concentration of Green and White were 20 mg/ml.
Statistical analysis
T-tests were done with GraphPad t-test calculator and ANOVA was tested with statistics kingdom ANOVA calculator.
Result
Physicochemical parameters of tea
Different physic-chemical properties determine the quality of manufactured leaves. Moisture content, total ash content, crude fibres are different physic-chemical properties of tea.
Moisture Content (MC) is an important index of tea quality. In most tea processing methods, the last step of drying plays a decisive role in the tea's moisture content. Ash content in tea is closely related to quality. The lower the ash content in the tea, the better the tenderness of the raw material.
The moisture content of commercially available white tea is equivalent to sun dried tea and green tea with hotwater treated teas, that is also applicable for total ash contents (4.5-9%) and all within ISO and FSSAI parameter standard limits.
Determination of total polyohenol and flavonoid cotent of different tea samples
Total polyphenols are the main biochemical quality index of different tea. The antioxidant prperties of tea is responsible for this polyphenol content. Catechins like epigallocatechin gallate is mainly prevalent in fresh leaves, white and green teas but eventually they are getting oxidised or fermented during the tea processing (industrial or handcrafted) and are converted to tannins (polymerised polyphenols) like theaflavin, thearubigins. The favonoids are the special types of flavonoids which are also prevalent in different tea. This flavonids are upregulated in tea by different biotic and abiotic stresses and add different values like commercial qualities viz. aroma, colour and therapeutic parameters like antioxidants and antimicrobial values.
Figure 5 total polyphenol content of handmade and commercially available tea sample Figure 1 shows the total polyphenol contents are higher in hotwater sundries and market available green tea (520 ± 0.002 µg GAE/g and 550 ± 0.005 µg GAE/g respectively).
Figure 5. Total polyphenol content of handmade and commercially available tea sample.
Figure 6 also shows the highest total flavonoid content in commercially available green tea like 370 ± 0.0001 µg QE/g and almost similar to handcrafted hotwater and sundried tea samples and 350 ± 0.0003 µg QE/g.
Figure 6. Total flavonoid content of handmade and commercially available tea sample.
FTIR analysis
The nature of the chemical constituents of different teas could be estimated by different analytical techniques which include FTIR technique which determines the types of bonds and the derivatives of different active components like polyphenols.
FTIR scan (Figures 7-10) shows that Hot water and sundry tea shows transmittance at the wavelength range of 2843-3909 cm-1 including stretching of aromatic C-H bond (2840-2950), polyphenolic OH bond stretching (at the range of 3350-3490 cm-1), while containing most of the standard bands of quercetin and gallic acid, in case of shade dry and hotwater treated tea, the number of transmittance peaks are lower and similar to Epigallocatechin gallate ranging from 2735-3910 cm-1 indicating medium and sharp alcoholic bond stretching, but sundry handmade tea only contain three peaks of transmittance at 1015 cm-1, 1658 cm-1 indicating strong primary alcohol stretching, like polyphenol Gallic acid, 3417 cm-1 indicating strong broad OH bond stretching similar epigallocatechin gallate. Comparing with the commercially available White tea and sundry tea shows similar transmittance wavelength at around 3415-3417 cm-1. Commercially available green tea contains the peaks at the wavelength of 3773, 3418, 3197 cm-1 indicating medium and sharp OH bond stretching which are also observed in the standard quercetin, epigallocatechin gallate and gallic acid and observed in handmade hotwater shade dry and sundry tea but higher in the later.
Figure 7. FTIR analysis of hot water and sundry and hot water shade dry handmade tea.
Figure 8. FTIR analysis of sundry handmade tea.
Figure 9. FTIR analysis of white tea and green tea.
Figure 10. FTIR analysis of standard gallic acid. Quercetin and epigallocatechin gallate.
Spectrophotometric scan analysis
Different active metabolitesin tea like polyhenols have absorption maxima within the UV range (200-400 nm). The spectrophotometric scan within this region of spectra could indentify the presence of signature active marker metabolites which could be confirmed further with the statndard and their absorption maxima (like epigallocatechin gallate, gallic acid).
Spectrophotometric scan (Figures 11-13) shows that by comparing the absorption maxima with Gallic acid standard the peaks are present and defined at 210 nm and 274 nm in handmade hotwater sundry and shade dry tea samples but quite diffused in only sundry samples, and the absorption peaks are not well defined in commercially available white and green tea. The absorption as O.D values are given in Table 2.
Figure 11. Spectrophotometric scan of hot water shade dry and hot water sundry samples.
Figure 12. Spectrophotometric scan of gallic acid standard and sundry samples.
Figure 13. Spectrophotometric scan of white tea and green tea.
| Sample | Absorbance |
| Gallic acid (1mg/ml) | 210 nm-1.62 274 nm-0.80 |
| Hot water+sundry | 210 nm-1.63 274 nm-0.68 |
| Hot water+shade dry | 210 nm-1.45 274 nm-0.55 |
| Sundry | 210 nm-1.75 274 nm-1.45 |
Table 2. Absorbance maxima and absorbance of spectrophotometric scan.
HPLC analysis
HPLC is the main bioanalytical technique to identify the signature soluble flavonoids like rutin, catechins in the tea, thus provide the information about the types of manufactured tea and its active components
Rutin is taken as standard showing characteristic peak at 7.414 minute retention time (A.U 0.095-concentration 1 mg/ml), sundry handmade tea retention time of peak at 7.421 minute 0.12 A. U, handmade hotwater and sundry peak retention time 7.548 minute A.U 0.24, hot water and shade dry 7.386 minute retention time peak absorbance 0.23 A.U.
At the retention time 7.203 the A.U of White tea is 0.03 and for green tea at 7.060 retention time the absorbance A.U is 0.02 indicating that the lower content of flavonoid glycoside like rutin which are seems to be higher in hand made teas (Figures 14-16).
Figure 14: a) HPLC scan of hot water and sundry and b) HPLC scan of rutin (standard).
Figure 15. a) HPLC scan of sundry and b) HPLC scan of hot water and shade dry.
Figure 16. HPLC chromatogram of commercially available white tea and green tea.
Thin layer chromatography analysis
Thin layer chromatography is another basic separation techniques of tea polyphenols from the crude extracts. Comparison of the Rf values with the standard flavonoids like quercetin not only identify their presence in the crude tea samples but also quantitatively could be ascertained by densitometric scanner (Figure 17).
Figure 17. Thin layer chromatography.
Tables 3 and 4 shows Volume% lane A is quercetin (1 mg/ml) is taken as 100%, lane B white tea=64%, lane C sundry=53.28%, lane D hot water and shade dry=131%, lane G hot water and sundry=139%. Table 5 shows lane a quercetin 100%, Lane D green tea=132%.
The observation shows the volume% of quercetin taken as standard (1 mg/ml is taken as 100%), the hot water sundry and hot water shade dry are similar to commercially available green tea samples and only sundry has volume% similar to commercially available white tea.
| Number | Lane A | Lane B | Lane C | Lane D | Lane G | |||||||||||||||
| Vol.% | Volume | Height | Area | Vol.% | Volume | Height | Area | Vol.% | Volume | Height | Area | Vol.% | Volume | Height | Area | Vol.% | Volume | Height | Area | |
| No | 100.000 | 1,56,82,503 | 25,179 | 1,369 | 64.215 | 1,00,70,515 | 28,828 | 407 | 53,283 | 83,56,170 | 27,729 | 481 | 139.206 | 2,18,30,960 | 29,111 | 1,073 | 131.342 | 2,05,97,639 | 24,319 | 1,739 |
| No 2 | 72,865 | 1,14,27,049 | 27,849 | 451 | ||||||||||||||||
Table 3. Thin layer chromatography.
| Lane A | Lane D | |||||||
| Number | we% | Volume | Height | Area | Vet% | Visiume | Height | Area |
| No 1 | 100.000 | 79,724 | 543 | 64 | 132,068 | 1.05.290 | 161 | 829 |
| No 2 | ||||||||
Table 4. Densitometric scan of thin layer chromatography.
Analysis of antioxidant potential
Different types of tea have different extent of antioxidant values. The antioxidant values are important to show the therapeutic qualities of tea. The active metabolites like polyphenols viz. flavonoids are responsible to show such therapeutic potentials.
Figure 18 shows highest antioxidant potential (82.1 ± 0.01%) in hotwater sundry similar to commercially available green tea (89 ± 0.01%) indicating higher therapeutic potentials.
Figure 18. Antioxidant potential of different tea sample.
Determination of commercial qualities of tea
The commercial qualities of tea are determined by different parametres like aroma, color, pH, catechin content etc. E-nose is the device which could represent the total volatile components indicating aroma quality of tea represented by TS (Total Score) and NI (Nor-aroma Index). The colour or hue of the tea could also be determined by spectrophotometrically. Total catechins is index of the good quality (health benefits) tea and pH of tea determines different types of manufactured tea differential levels of active components.
Table 5 shows the similar types of colour, catechin content, pH in sundry with white tea and hotwater sun and shade dried manufactured teas are similar to green tea with respect to all those parameters.
| Samples | E-nose score (T.S and N.I) | COLOR at 460 nm /mg fresh wt. | Catechin content % | pH |
| White tea | 1.9 ± 0.01, 10 ± 0.023 | 0.53 ± 0.001 | 17 ± 0.13 | 9.7 |
| Green tea | 3 ± 0.01, 13 ± 0.045 | 1.1 ± 0.002 | 25 ± 0.2 | 7 |
| Sundry | 1.8 ± 0.03, 9.5 ± 0.05 | 0.5 ± 0.001 | 16.5 ± 0.13 | 9.5 |
| Hotwate+sundry | 2.8 ± 0.02, 12 ± 0.023 | 1 ± 0.005 | 26.8 ± 0.19 | 7.1 |
| Hotwater+shadedry | 2.5 ± 0.03, 12 ± 0.001 | 0.95 ± 0.001 | 24.2 ± 0.13 | 7.2 |
Table 5. Color, catechin content and pH of different tea.
Analysis of antimicrobial potential of different tea
The antimicrobial potential is another therapeutic index of tea. Different types of manufacturing processes could differentiate different types and content of active metabolites like polyphenols viz. flavonoids which are reflected in antimicrobial potential.
The antimicrobial potential (Figures 19-21) also reflects the observation that the values are similar for Hotwater and sundry and shade dry with commercially available Green tea and only sundry has similar potential with White tea.
Figure 19. Antimicrobial activities of different handcrafted tea against E. coli.
Figure 20. Antimicrobial activities of white and green tea against E. coli.
Figure 21. Comparison of antimicrobial potential against E. coli (in terms of zone of inhibition in mm).
Analysis of quality parameters (therapeutic and commercial) of different handcrafted tea for five months
The quality of manufactured tea should not only be determined at the initial period but should be continuously monitored during the period of consumption. The deterioration in quality parameters like commercial qualities (viz. colour, catechins, aroma) and therapeutic qualities like antioxidant and antimicrobial potential is the characters of different types of manufactured tea. The consistency of the retention of quality parametres during storage is the determinant of the shelf life and the choice of commercial value of small tea growers who are involved to make such handcrafted tea-a significant value as a tea manufacturer. Here the packaging was done in plastic zip pouch for five months (January 2024 to June 2024).
Figure 22 shows that the percent quality reduction (a collative value of all the parametres) is higher in only sundried tea which is somehow the signature of the commercially available only withered white tea.
Figure 22. Percent reduction in quality parameters.
The statistical data (Figure 23) for validation and calculation by ANOVA calculator with three datasets of total polyphenol total flavonoid and total antioxidant potential shows the significant correlation p<0.005.
Figure 23. ANOVA calculation table.
The statistical data for validation and calculation by ANOVA calculator with three datasets of total polyphenol total flavonoid and total antioxidant potential shows the significant correlation p<0.005
Figure 24 shows that the significant polyphenol is directly correlated with the specific antioxidant potential of differentially manufactured tea.
Figure 24. T-test calculation table.
Discussion
Differential physico-chemical and commercial qualities of different handcrafted tea
Table 1 shows that the physic-chemical parameters like ash content and moisture content of the handcrafted teas are at per the ISO limits and FSSAI regulations.
The moisture content of the sundried tea is similar to white tea and hotwater (shade and sundried) treated teas have similar parameters to commercially available green tea. Cheng et al., has also demonstrated that in handmade tea there are variation in ash content and moisture content in sundried tea.
Roshanak et al., has described this types of changes of different handcfarted tea in quality parameters like color in different types of tea made by different drying methods.
The comparison of active metabolites in different types of handcrafted tea
The active metabolites are mainly polyphenols (like gallic acid), catechins (like epigallocatechin gallate), flavonoids (like rutin, quercetin), the contents are identified, differentiated with various qualitative and quantitative analytical methods like thin layer chromatography, HPLC, FTIR, spectrophotometric scan etc in different types of handcrafted tea.
Figures 5 and 6 show that the total polyphenol and flavonoid content is highest for hotwater and sundried tea and almost similar to commercially available green tea and only sundried tea shows the similar trend as commercially available white tea. Change in polyphenol like quality parameters in different types of tea under different drying processes were described by Roshanak et al., Etseki et al., had identified different geographic based green teas with FTIR fingerprinting pattern of active metabolites like polyphenols. Senthilkumar and Thirumal, had described this type of transmittance pattern of polyohenolic components in green tea.
Ray et al., has also described similar spectrophotometric scan pattern in white and green tea which are similar here with only sundried and hotwater and sundried handcrafted tea here respectively.
Figures 14-16 shows the pattern of HPLC in different handcrafted tea. Wang et al., has described this type of HPLC pattern variation linked to flavonoids, polyphenols content in Pu-reh tea made by different drying processes.
Figure 17 shows the Thin layer chromatographic pattern of different handcrafted tea qualitatively and quantitatively. Ray et al., has described this type of pattern of thin layer chromatogram and densitometric scan of different types of tea.
Chan et al., has demonstrated the change in antioxidant potential in tea made by different drying processes which could be compared with the Figure 7 showing the differences among different types of handcrafted teas.
Differential therapeutic values of different types of handcrafted tea
The antioxidant and antimicrobial potentials are dependent on the content of the active metabolites which were identified and quantified by the above analytical techniques (by comparing with the standard). The differential values of antioxidant and antimicrobial potential of different types of handcrafted tea are corroborating such differential active metabolite content representing the therapeutic quality parameters.
Dincer and Baglam, has demonstrated the differential antimicrobial potential in different types of processed teas (different drying methods) which could be correlated with the data derived here with different handcrafted teas. Moreover, the data could be easily corroborated with all other data which show the differential active component (polyphenol viz. flavonoid) content.
Shelf life of different types of handcrafted tea
In five months periods after packaging (January 2024 to June 2024 in plastic zip pouch) the quality parameters like polyphenol content and antioxidant potential, there is reduction in percentage of all the differentially handcrafted teas which establishes the fact that according to Saha and Shyam Choudhury, the same kind of trend is followed for white and green tea where the reduction percentage is highest in white tea which is equivalent to only sundried (as withered) handmade tea here. High moisture content might be the responsible physico-chemical parameter to reduce the therapeutic and commercial quality parameters in handcrafted teas under different drying methods of handcrafted tea. The higher shelf life by retaining the quality parametres (commercial and therapeutic both) with lower reduction percentage is maximum observed in hotwater and sundried handcrafted tea (almost similar to commercially available green tea), establishing the efficacy of the handcrafted manufacturer viz. small tea growers (here VVTEA farm, Fatapukur, Jalpaiguri).
Statistical validation of differentially handcrafted tea and their quality components: Correlation with therapeutic potential
Figure 23 shows the commercial quality components of tea like higher polyphenol and flavonoid content are responsible for higher antioxidant potential (therapeutic potential) in Green and hotwater sundried handcrafted tea, which is statistically valid (by ANOVA testing) to support superior quality of hotwater sundried handcrafted tea. Figure 24 also correlates the specific polyphenol content with the corresponding antioxidant potential (by t test).
So the overall enhancement of the commercial and therapeutic quality parameters enhancement in hotwater and sundried tea is summarized in Figure 25.
Figure 25. Summary of handcrafted methods for quality enhancement.
Conclusion
Handcrafted hotwater sundried tea shows all the good commercial values (like color, ash content, flavonoid content, polyphenol, catechin content, flavour in terms of E-nose N.I and T.S values) and therapeutic potential (antimicrobial and antioxidant potentials) are higher and similar to commercially available green tea whereas all those parameters are similar for commercially available white tea as sundried tea. This establishes the fact that the different handcrafted teas are superior in nature and comparable interms of commercial and therapeutic qualities with respect to commercially available marketed tea.
The Unique Selling Price (USP) of this paper is that the method of hot water sundrying is ideal for maintain the quality parameters of the tea which is cheap and at the same time highly effective for commercialization.
Acknowledgement
The project is done with the help of the intramural fund disbursed by St. Xavier’s College, Kolkata (Project Reference no. (IMSXC2023-24/002)
References
- Halder H, Sahoo RR, Guha S, et al. Identification and characterization of the antimicrobial and active components of tea (Camellia sinensis). J Pharm Biol Sci. 2020;15(1):51-8.
- Wang C, Han J, Pu Y, et al. Tea (Camellia sinensis): a review of nutritional composition, potential applications, and Omics Research. Appl Sci. 2022;12(12):5874.
- Salman S, Oz G, Felek R, et al. Effects of fermentation time on phenolic composition, antioxidant and antimicrobial activities of green, oolong, and black teas. Food Biosci. 2022;49:101884.
- Nag A, Dhull N, Gupta A. Evaluation of tea (Camellia sinensis L.) phytochemicals as multi-disease modulators, a multidimensional in silico strategy with the combinations of network pharmacology, pharmacophore analysis, statistics and molecular docking. Mol Divers. 2023;27(1):487-509.
[Crossref] [Google Scholar] [PubMed]
- Maulana H, Prawira-Atmaja MI, Hamdini N, et al. Changes of chemical contents during the withering process of white tea. IOP Conf Ser: Earth Environ Sci. 2020;443:012023.
- Cisneros M, Lante A. Tea from the food science perspective: An overview. Open Biotechnol J. 2020;14:78-83.
- Chowdhury A, Mandal P, Chowdhury A, et al. Prospects and problems of small tea growers in Terai and Duars of West Bengal, India. Int J Curr Adv Res. 2016;5(2):587-90.
- Budiyoko B, Prayoga A, Rusdah R, et al. Business Model for Small-Scale Artisan Tea Family Business. Int J Appl Bus 2023;8.
- Roshanak S, Rahimmalek M, Goli SA. Evaluation of seven different drying treatments in respect to total flavonoid, phenolic, vitamin C content, chlorophyll, antioxidant activity and color of green tea (Camellia sinensis or C. assamica) leaves. J Food Sci Technol. 2016;53:721-9.
[Crossref] [Google Scholar] [PubMed]